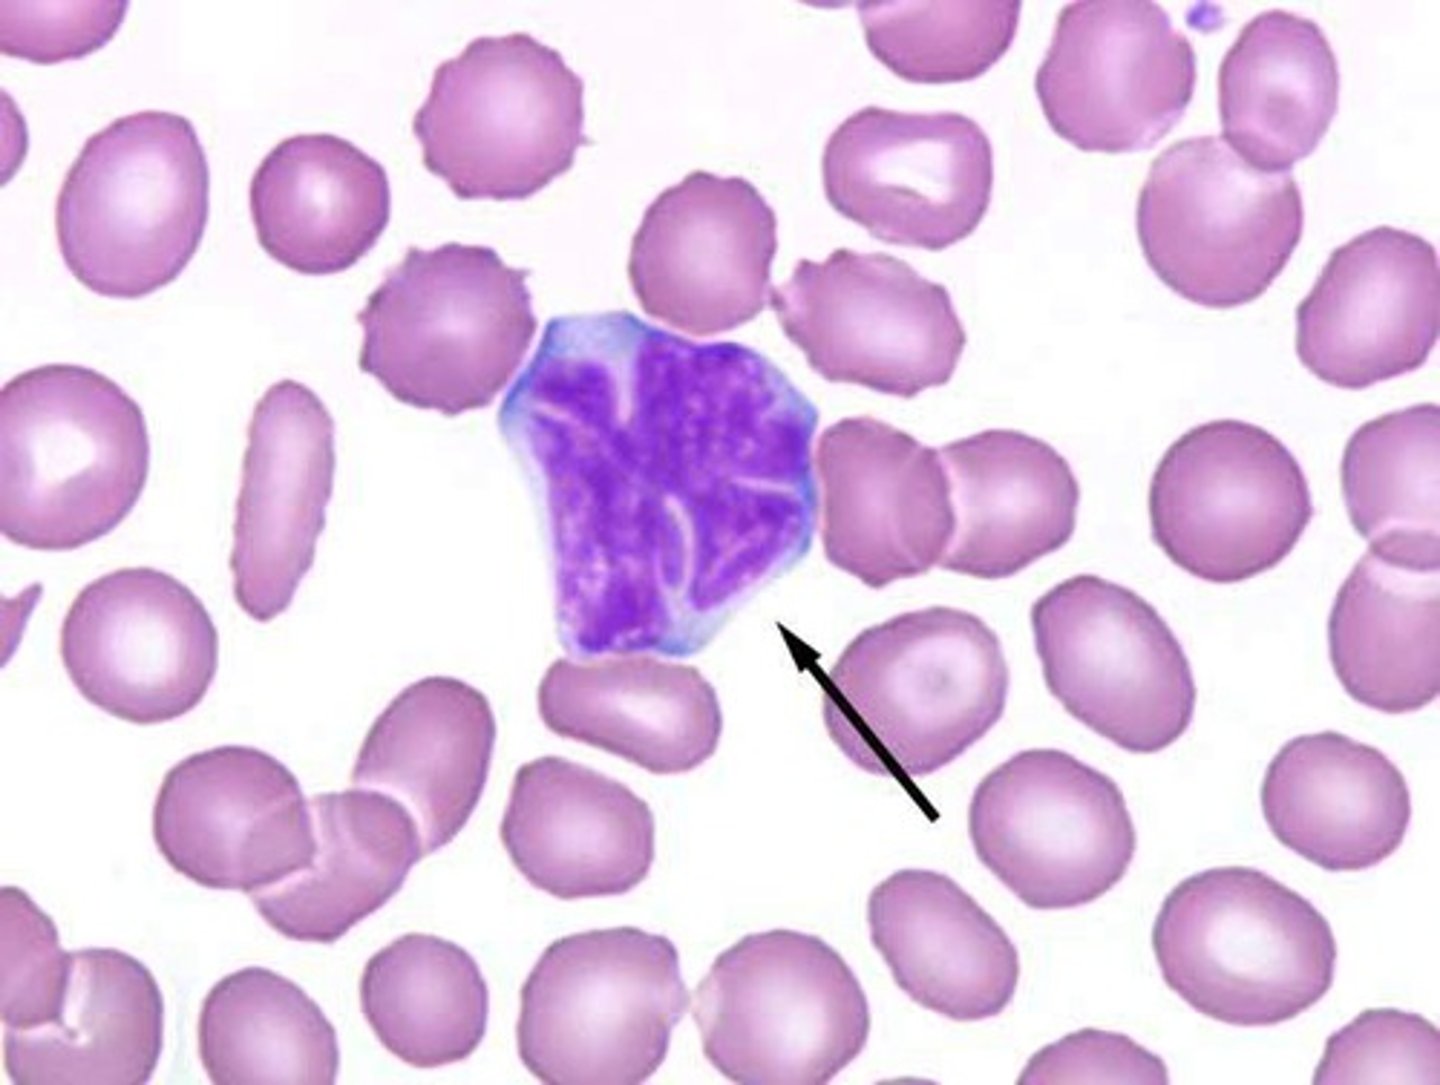
<p>-neoplastic cells show a cerebriform appearance on morphology</p>

SDL 17: peripheral T cell and NK cell neoplasms
1/12
There's no tags or description
Looks like no tags are added yet.
Name | Mastery | Learn | Test | Matching | Spaced | Call with Kai |
|---|
No study sessions yet.
13 Terms
peripheral T cell lymphoma not otherwise specified
a heterogeneous group of predominantly nodal T cell lymphomas lacking specific features
-mature T cell lymphoma that does not meet criteria for other T cell lymphoma entities
angioimmunoblastic T cell lymphoma
aggressive form of peripheral T-cell lymphoma in which proliferation of atypical lymphoid cells is combined with the formation of the arborizing high endothelial venules and a diffuse proliferation of follicular dendritic cells.
Angioimmunoblastic T-Cell Lymphoma (AITL)
-medium sized neoplastic T cells with moderate and abundant pale cytoplasm
-pronounced proliferatioin of arborizing high endothelial venules

anaplastic large cell lymphoma
rare type of mature T-cell tumors, characterized morphologically by large lymphoid cells with pleomorphic or horseshoe-shaped nuclei.

t(2;5)(p23;q35) translocation, involving ALK, the anaplastic lymphoma kinase gene
translocation and gene associated with anaplastic large cell lymphoma
destructive nasal or midline facial tumor.
most common clinical presentation of a extranodal peripheral T cell lymphoma
extranodal peripheral T cell lymphoma
A striking feature is the angiocentric distribution of the tumor cells, which surround and invade small vessels, leading to destruction of vessel walls, thrombosis and extensive ischemic necrosis.

mycosis fungoides and Sezary syndrome
primary cutaneous lymphomas that occur on the skin without evidence of extracutaneous disease at the time of diagnosis
Mycosis Fungoides
can present as a chronic itch
progresses slowly over years from patches to plaques and may eventually form tumors
generalized erythroderma with pruritus, lymphadenopathy, and leukemic involvement of malignant T cells that typically match the clone in the skin.
what is the triad of Sezary syndrome?
sezary syndrome
-neoplastic cells show a cerebriform appearance on morphology
adult T cell leukemia/lymphoma
peripheral T cell neoplasm associated with infection by the human T-lymphotropic virus, type 1(HTLV-1).

large granular lymphocyte leukemia
a clonal disease of the large granular lymphocyte characterized by peripheral blood and marrow lymphocytic infiltration with LGLs, splenomegaly, and cytopenias, most commonly neutropenia
